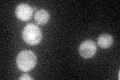
YKL130C
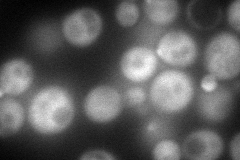
YKL130C
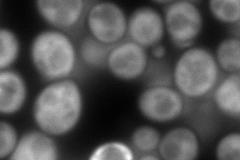
YKL130C
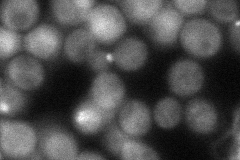
YKL130C
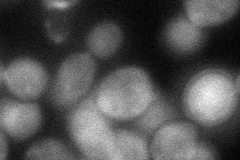
YKL130C

View description
RNA-binding protein that binds specific mRNAs and interacts with She3p; part of the mRNA localization machinery that restricts accumulation of certain proteins to the bud
Localization:
Intensity:
Fold change:
Significance:
-
C’ GFP library in SD
cytosol36.13 -
N' NOP1pr-GFP in SD
cytosol,bud143.135 -
N' TEF2pr-mCherry in SD
cytosol267.126 -
N' NATIVEpr-GFP in SD
bud50.4151 -
N' TEF2pr-VC and Cyto-VN in SD
cytosol59.6153 -
C’ GFP library in SD+DTT

cytosol29.650.82No -
C’ GFP library in SD+H2O2

cytosol31.040.85No -
C’ GFP library in Starvation Media

cytosol17.420.48No -
C’ GFP library on the background of Pup2-DaMP

cytosol -
C’ GFP library on the background of CCT mutant

cytosol30.54630.845279No
